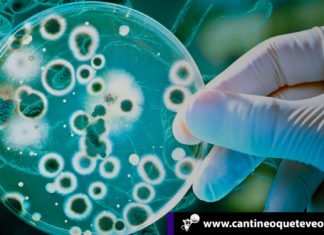
La guerra de los mundos o nuestra alianza con las bacterias Las bacterias - Cantineoqueteveonews

¿Cómo reconocer el Hamparte según el artista español Antonio García Villarán?
Lo más refrescante de las claves para reconocer el Hamparte según Antonio García Villarán es el humor. Este artista y youtuber español ha propuesto una mirada más honesta y limpia a la obras de...
Epidemiología: La Gripe Española nació en los Estados Unidos
En el epílogo de la Primera Guerra Mundial, uno de los mayores derramamientos de sangre de la historia, la humanidad conoció a la Gripe Española, un asesino silencioso y misterioso que llegó como se...
La guerra de los mundos o nuestra alianza con las bacterias
La nanomedicina ya encontró la fantástica estrategia de utilizar a los virus como agentes secretos que inducen al suicidio de las bacterias. Como en la novela La guerra de los mundos la invasión de las...
La pedofilia, la ciencia y la vocación de los hombres
En los tiempos que vivimos el estudio de la pedofilia, incluso la sola palabra pedófilo, nos remite irremediablemente al sacerdocio. En otras condiciones, la misma palabra sugería la conducta sexual de delincuentes o de...
Así se vivió la “La Ruta Condesa” en el Occidente del país
La marca de línea blanca Condesa, sorprendió a las familias venezolanas del occidente del país, dándose cita en los aliados comerciales de la zona donde compartieron con clientes que se acercaron a “La Ruta...
¿Cómo es el paradoxurus hermaphroditus precursor del kopi luwak cafe?
“Ahí viene de nuevo. Es el mismo hombre de todos los días, el que viste la franela que dice ‘kopi luwak cafe’. A pesar del desprecio que siento por él y por todos los...
Ventajas de ser un koala vs cuidado de perros en el III Mundo
Un perspicaz usuario de las redes sociales propuso una perversa estrategia para procurar mayores atenciones y cuidados de perros disfrazándolos de koalas. Ciertamente ser un koala tiene sus ventajas y muchas. Los recientes incendios en...
Revistas científicas depredadoras pescan investigadores en español
Le parecía que había llegado el momento de publicar. Sus colegas científicos ya lo habían hecho y se lo recomendaban. Tenía que considerar las revistas científicas en español disponibles y realizar su aporte a...
Ancas de rana es el pollo más sabroso de la montaña francesa
Nadie se explica cómo sobreviven las desacreditadas ancas de rana, usadas en tiempos remotos para hacer el mal, desacreditadas y tantas veces calificadas como asquerosas.
En la antigüedad le atribuyeron poderosas y extraordinarias cualidades. Tanto...
Barquisimeto fue protagonista de “La Ruta Condesa”
Para dar inició al año 2020, la marca de línea blanca Condesa, sorprendió a las familias venezolanas del occidente del país, dándose cita en los aliados comerciales de la ciudad de Barquisimeto, donde compartieron...